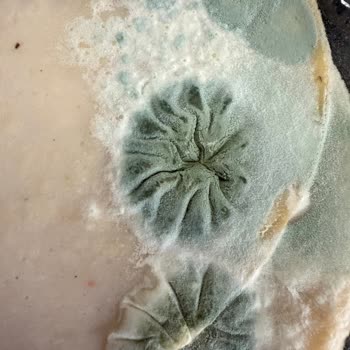
Son Kullanma Tarihi Geçmemiş Üründe Şok Edici Manzara

Namet Dana Salam Paketi Boş Geldi Şok Market'ten Hızlı Telafi Talebi

07.05.2026 tarihinde saat 13.02 civarında Şok market uygulaması üzerinden verdiğim siparişte yer alan “Namet dana salam ...60 g” ürünü, elime ulaştıktan sonra dolabıma yerleştirirken paketin içinin tamamen boş olduğunu fark ettim. Pakette hiçbir açılma, yırtılma, deformasyon yoktu, görünüş olarak gayet